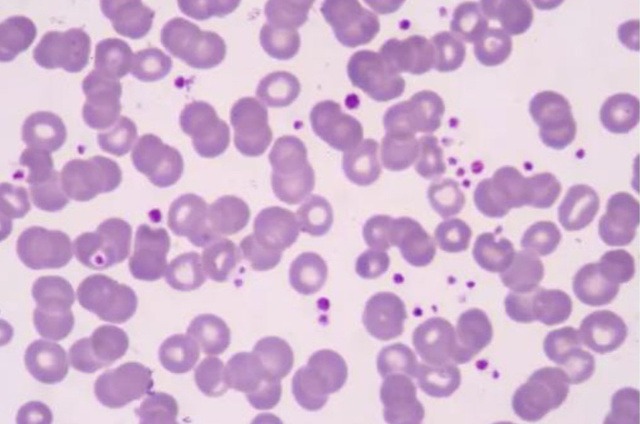

工作细胞中Couple的故事-d082
每当我看工作细胞的时候。
我的闺蜜就会给我发一些图片。
损友。
3803、2153准备好面对疾风了吗?
红血球AE3803总感觉有不好的事情要发生…
红血球AA2153同感


真身了
红血球AE3803……………
红血球AA2153……………
下一个是:1146、1196
白血球U1196要干嘛直说。
白血球U1146有种不祥的预感……


真不错
这个不用说都知道是谁了吧。
你们的老婆……血小板

巨噬姐姐…
我已经发不下去了。
想看的话可以自行准备一个显微镜。
再见
求评论求鲜花求收藏求关注。
(这真的对我很重要)